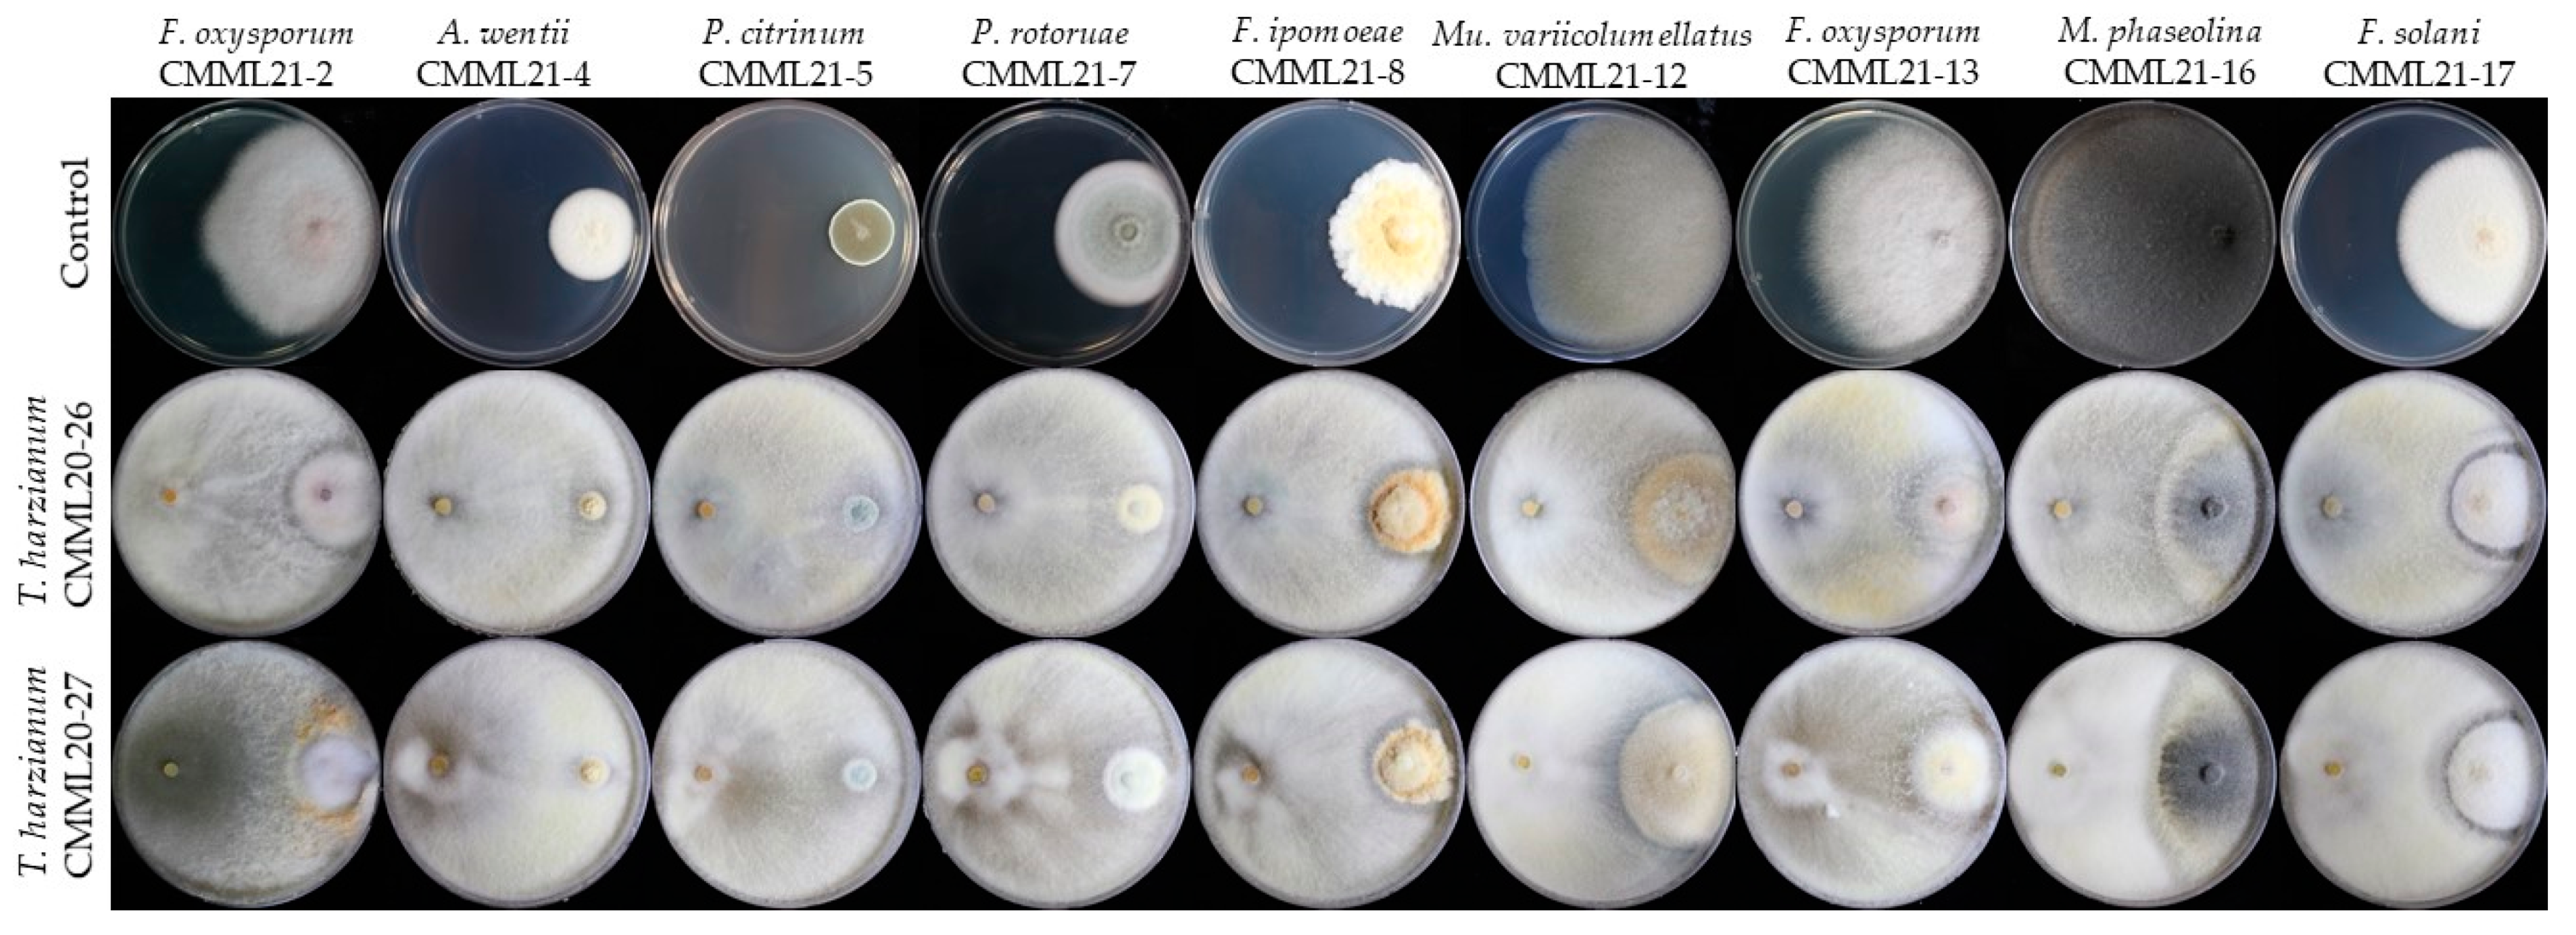

Fungi Associated with Postharvest Diseases of Sweet Potato Storage Roots and In Vitro Antagonistic Assay of Trichoderma harzianum against the Diseases
Abstract
:1. Introduction
2. Materials and Methods
2.1. Fungal Isolation
2.2. DNA Extraction, PCR Amplification, and Sequencing
2.3. Molecular Phylogeny
2.4. Morphology
2.5. Pathogenicity and Reisolation
2.6. In Vitro Biocontrol Activity
3. Results
3.1. Associated Pathogenic Fungi
3.2. Molecular Phylogeny
3.3. Morphology
3.4. Taxonomy: Aspergillus wentii CMML21–4
3.5. Taxonomy: Penicillium rotoruae CMML21–7
3.6. Pathogenicity
3.7. In Vitro Antifungal Activity
4. Discussion
Supplementary Materials
Author Contributions
Funding
Institutional Review Board Statement
Informed Consent Statement
Data Availability Statement
Conflicts of Interest
References
- Jiang, L.; Jeong, J.C.; Lee, J.-S.; Park, J.M.; Yang, J.-W.; Lee, M.H.; Choi, S.H.; Kim, C.Y.; Kim, D.-H.; Kim, S.W.; et al. Potential of Pantoea dispersa as an Effective Biocontrol Agent for Black Rot in Sweet Potato. Sci. Rep. 2019, 9, 16354. [Google Scholar] [CrossRef] [PubMed] [Green Version]
- Nedunchezhiyan, M.; Byju, G.; Jata, S.K. Sweet Potato Agronomy. Fruit Veg. Sereal Sci. Biotechnol. 2012, 6, 1–10. [Google Scholar]
- Paul, N.C.; Park, W.; Lee, S.; Chung, M.N.; Lee, H.-U.; Yang, J.-W. Occurrence of Sweetpotato (Ipomoea batatas) Wilt and Surface Rot Disease and Determining Resistance of Selected Varieties to the Pathogen in Korea. Plants 2020, 9, 497. [Google Scholar] [CrossRef] [PubMed]
- Wang, C.-J.; Wang, Y.-Z.; Chu, Z.-H.; Wang, P.-S.; Liu, B.-Y.; Li, B.-Y.; Yu, X.-L.; Luan, B.-H. Endophytic Bacillus Amyloliquefaciens YTB1407 Elicits Resistance against Two Fungal Pathogens in Sweet Potato (Ipomoea batatas (L.) Lam.). J. Plant Physiol. 2020, 253, 153260. [Google Scholar] [CrossRef]
- Sugri, I.; Maalekuu, B.K.; Gaveh, E.; Kusi, F.; Lamini, S. Assessment of Low-Cost Postharvest Techniques to Reduce Storage Losses in Sweet Potato. Sustain. Agric. Res. 2020, 9, 17. [Google Scholar] [CrossRef]
- Clark, C.A.; Moyer, J.W. Black rot. In Compendium of Sweetpotato Diseases, Pests, and Disorders; APS Press: St. Paul, MN, USA, 2013; pp. 29–33. [Google Scholar]
- Sun, Y.; Li, M.; Wang, Y.; Li, L.; Wang, M.; Li, X.; Xu, M.; Loake, G.J.; Guo, M.; Jiang, J. Ceratocystis fimbriata Employs a Unique Infection Strategy Targeting Peltate Glandular Trichomes of Sweetpotato (Ipomoea batatas) Plants. Phytopathology® 2020, 110, 1923–1933. [Google Scholar] [CrossRef]
- Bovell-Benjamin, A.C. Sweet Potato: A Review of its Past, Present, and Future Role in Human Nutrition. In Advances in Food and Nutrition Research; Elsevier B.V.: Amsterdam, The Netherlands, 2007; Volume 52, pp. 1–59. ISBN 978-0-12-373711-3. [Google Scholar]
- El Sheikha, A.F.; Ray, R.C. Potential Impacts of Bioprocessing of Sweet Potato: Review. Crit. Rev. Food Sci. Nutr. 2017, 57, 455–471. [Google Scholar] [CrossRef]
- Paul, N.C.; Nam, S.-S.; Kachroo, A.; Kim, Y.-H.; Yang, J.-W. Characterization and Pathogenicity of Sweet Potato (Ipomoea batatas) Black Rot Caused by Ceratocystis fimbriata in Korea. Eur. J. Plant Pathol. 2018, 152, 833–840. [Google Scholar] [CrossRef]
- Scruggs, A.C.; Quesada-Ocampo, L.M. Etiology and Epidemiological Conditions Promoting Fusarium Root Rot in Sweetpotato. Phytopathology® 2016, 106, 909–919. [Google Scholar] [CrossRef] [Green Version]
- Yang, Y.; Fang, B.; Feng, S.; Wang, Z.; Luo, Z.; Yao, Z.; Zou, H.; Huang, L. Isolation and Identification of Trichoderma asperellum, the Novel Causal Agent of Green Mold Disease in Sweetpotato. Plant Dis. 2021, 105, 1711–1718. [Google Scholar] [CrossRef]
- Dania, V.O.; Thomas, A.S. Bioactivity and Phytochemical Composition of Moringa Oleifera in the Management of Fungal Rot Disease of Orange-Fleshed Sweetpotato. Niger. J. Mycol. 2019, 11, 26–45. [Google Scholar]
- Mello, J.F.; Brito, A.C.Q.; Vieira, J.C.B.; Câmara, M.P.S.; Michereff, S.J.; Souza-Motta, C.M.; Machado, A.R. Identification and Pathogenicity of Botryosphaeriaceae Species Associated with Root and Stem Rot of Sweet Potato in Brazil. Plant Pathol. 2021, 70, 1601–1615. [Google Scholar] [CrossRef]
- Yang, J.-W.; Nam, S.-S.; Lee, H.-U.; Choi, K.-H.; Hwang, S.-G.; Paul, N.C. Fusarium Root Rot Caused by Fusarium solani on Sweet Potato (Ipomoea batatas) in South Korea. Can. J. Plant Pathol. 2018, 40, 90–95. [Google Scholar] [CrossRef]
- Paul, N.C.; Hwang, E.-J.; Nam, S.-S.; Lee, H.-U.; Lee, J.-S.; Yu, G.-D.; Kang, Y.-G.; Lee, K.-B.; Go, S.; Yang, J.-W. Phylogenetic Placement and Morphological Characterization of Sclerotium rolfsii (Teleomorph: Athelia rolfsii) Associated with Blight Disease of Ipomoea batatas in Korea. Mycobiology 2017, 45, 129–138. [Google Scholar] [CrossRef] [Green Version]
- Loebenstein, G.; Thottappilly, G. The Sweet Potato; Springer: Dordrecht, The Netherlands, 2009. [Google Scholar]
- Harter, L.L.; Weimer, J.L.; Adams, J.M.R. Sweet Potato Storage Rots. J. Agric. Res. 1918, 15, 337–368. [Google Scholar]
- Arancibia, R.A.; Main, J.L.; Clark, C.A. Sweetpotato Tip Rot Incidence Is Increased by Preharvest Applications of Ethephon and Reduced by Curing. Hortte 2013, 23, 288–293. [Google Scholar] [CrossRef] [Green Version]
- Da Silva, W.L.; Clark, C.A. Infection of Sweetpotato by Fusarium solani and Macrophomina phaseolina Prior to Harvest. Plant Dis. 2013, 97, 1636–1644. [Google Scholar] [CrossRef] [Green Version]
- Yuan, B.; Xue, L.; Zhang, Q.; Kong, W.; Peng, J.; Kou, M.; Jiang, J. Essential Oil from Sweet Potato Vines, a Potential New Natural Preservative, and an Antioxidant on Sweet Potato Tubers: Assessment of the Activity and the Constitution. J. Agric. Food Chem. 2016, 64, 7481–7491. [Google Scholar] [CrossRef] [PubMed]
- Hopfer, H.; Buffon, P.A.; Ebeler, S.E.; Heymann, H. The Combined Effects of Storage Temperature and Packaging on the Sensory, Chemical, and Physical Properties of a Cabernet Sauvignon Wine. J. Agric. Food Chem. 2013, 61, 3320–3334. [Google Scholar] [CrossRef] [PubMed]
- Ji, S.H.; Paul, N.C.; Deng, J.X.; Kim, Y.S.; Yun, B.-S.; Yu, S.H. Biocontrol Activity of Bacillus amyloliquefaciens CNU114001 against Fungal Plant Diseases. Mycobiology 2013, 41, 234–242. [Google Scholar] [CrossRef] [PubMed] [Green Version]
- Cubero, O.F.; Crespo, A.; Fatehi, J.; Bridge, P.D. DNA Extraction and PCR Amplification Method Suitable for Fresh, Herbarium-Stored, Lichenized, and Other Fungi. Plant Syst. Evol. 1999, 216, 243–249. [Google Scholar] [CrossRef]
- Staats, M. Molecular Phylogeny of the Plant Pathogenic Genus Botrytis and the Evolution of Host Specificity. Mol. Biol. Evol. 2004, 22, 333–346. [Google Scholar] [CrossRef] [PubMed] [Green Version]
- Aveskamp, M.M.; Verkley, G.J.M.; de Gruyter, J.; Murace, M.A.; Perelló, A.; Woudenberg, J.H.C.; Groenewald, J.Z.; Crous, P.W. DNA Phylogeny Reveals Polyphyly of Phoma Section Peyronellaea and Multiple Taxonomic Novelties. Mycologia 2009, 101, 363–382. [Google Scholar] [CrossRef] [Green Version]
- Kumar, S.; Stecher, G.; Li, M.; Knyaz, C.; Tamura, K. MEGA X: Molecular Evolutionary Genetics Analysis across Computing Platforms. Mol. Biol. Evol. 2018, 35, 1547–1549. [Google Scholar] [CrossRef] [PubMed]
- Thompson, J.D.; Gibson, T.J.; Plewniak, F.; Jeanmougin, F.; Higgins, D.G. The CLUSTAL_X Windows Interface: Flexible Strategies for Multiple Sequence Alignment Aided by Quality Analysis Tools. Nucleic Acids Res. 1997, 25, 4876–4882. [Google Scholar] [CrossRef] [Green Version]
- Hall, T.A. BioEdit: A User-Friendly Biological Sequence Alignment Editor and Analysis Program for Windows95/98/NT. Nucleic Acids Symp. Ser. 1999, 41, 95–98. [Google Scholar]
- Chilvers, M.I.; Jones, S.; Meleca, J.; Peever, T.L.; Pethybridge, S.J.; Hay, F.S. Characterization of Mating Type Genes Supports the Hypothesis that Stagonosporopsis chrysanthemi is Homothallic and Provides Evidence That Stagonosporopsis tanaceti is Heterothallic. Curr. Genet. 2014, 60, 295–302. [Google Scholar] [CrossRef]
- Rayner, R.W. A Mycological Colour Chart; Commonwealth Mycological Institute: Surrey, UK, 1970. [Google Scholar]
- Wonglom, P.; Sunpapao, A. Fusarium incarnatum Is Associated with Postharvest Fruit Rot of Muskmelon (Cucumis melo). J. Phytopathol. 2020, 168, 204–210. [Google Scholar] [CrossRef]
- Wang, M.M.; Chen, Q.; Diao, Y.Z.; Duan, W.J.; Cai, L. Fusarium incarnatum-equiseti Complex from China. Persoonia 2019, 43, 70–89. [Google Scholar] [CrossRef] [Green Version]
- Avila, C.F.; Moreira, G.M.; Nicolli, C.P.; Gomes, L.B.; Abreu, L.M.; Pfenning, L.H.; Haidukowski, M.; Moretti, A.; Logrieco, A.; Del Ponte, E.M. Fusarium incarnatum-equiseti Species Complex Associated with Brazilian Rice: Phylogeny, Morphology and Toxigenic Potential. Int. J. Food Microbiol. 2019, 306, 108267. [Google Scholar] [CrossRef] [PubMed]
- Xia, J.W.; Sandoval-Denis, M.; Crous, P.W.; Zhang, X.G.; Lombard, L. Numbers to Names—Restyling the Fusarium incarnatum-equiseti Species Complex. Persoonia 2019, 43, 186–221. [Google Scholar] [CrossRef]
- Houbraken, J.A.M.P.; Frisvad, J.C.; Samson, R.A. Taxonomy of Penicillium citrinum and Related Species. Fungal Div. 2010, 44, 117–133. [Google Scholar] [CrossRef] [Green Version]
- Lubbehusen, T.L.; Nielsen, J.; McIntyre, M. Characterization of the Mucor circinelloides Life Cycle by On-Line Image Analysis. J. Appl. Microbiol. 2003, 95, 1152–1160. [Google Scholar] [CrossRef] [PubMed] [Green Version]
- Wagner, L.; Stielow, J.B.; de Hoog, G.S.; Bensch, K.; Schwartze, V.U.; Voigt, K.; Alastruey-Izquierdo, A.; Kurzai, O.; Walther, G. A New Species Concept for the Clinically Relevant Mucor circinelloides Complex. Persoonia 2020, 44, 67–97. [Google Scholar] [CrossRef] [PubMed]
- Meena, R.P.; Kadam, V.A. Characterization of Macrophomina phaseolina Associated with Leaf Blight Disease on Chlorophytum borivilianum Santapau & R.R. Fern. and Its Fungicidal Susceptibility. J. Appl. Res. Med. Aromat. Plants 2021, 20, 100288. [Google Scholar] [CrossRef]
- Pandey, A.K.; Burlakoti, R.R.; Rathore, A.; Nair, R.M. Morphological and Molecular Characterization of Macrophomina phaseolina Isolated from Three Legume Crops and Evaluation of Mungbean Genotypes for Resistance to Dry Root Rot. Crop Prot. 2020, 127, 104962. [Google Scholar] [CrossRef]
- Popović, T.; Blagojević, J.; Aleksić, G.; Jelušić, A.; Krnjajić, S.; Milovanović, P. A Blight Disease on Highbush Blueberry Associated with Macrophomina phaseolina in Serbia. Can. J. Plant Pathol. 2018, 40, 121–127. [Google Scholar] [CrossRef] [Green Version]
- O’Callahan, D.; Vaidya, A.; Donaldson, L.; Singh, T. Penicillium rotoruae, a New Species from an In-Ground Timber Durability Test Site in New Zealand. Curr. Microbiol. 2020, 77, 4129–4139. [Google Scholar] [CrossRef]
- Ray, R.C.; Ravi, V. Post Harvest Spoilage of Sweetpotato in Tropics and Control Measures. Crit. Rev. Food Sci. Nutr. 2005, 45, 623–644. [Google Scholar] [CrossRef]
- Sarr, M.P.; Ndiaye, M.; Groenewald, J.Z.; Crous, P.W. Genetic Diversity in Macrophomina phaseolina, the Causal Agent of Charcoal Rot. Phytopathol. Mediterr. 2014, 53, 250–268. [Google Scholar]
- Stahr, M.; Quesada-Ocampo, L.M. Assessing the Role of Temperature, Inoculum Density, and Wounding on Disease Progression of the Fungal Pathogen Ceratocystis fimbriata Causing Black Rot in Sweetpotato. Plant Dis. 2020, 104, 930–937. [Google Scholar] [CrossRef]
- Ray, R.C.; Byju, G. Root Surface Culturable Microflora Associated with Post Harvest Spoilage of Sweet Potato (Ipomoea batatas L.). Adv. Hortic. Sci. 2003, 17, 176–180. [Google Scholar]
- Okungbowa, F.I.; Osagie, M. Mycoflora of Sun-Dried Sweet Potato (Ipomoea batatas L.) Slices in Benin City, Nigeria. Afr. J. Biotechnol. 2009, 8, 3326–3331. [Google Scholar]
- Dayal, T.R.; Scott, G.J.; Kurup, G.T.; Balagopalan, C. Sweetpotato in South Asia: Postharvest Handling, Storage, Processing, and Use; Revised Edition; International Potato Center: Lima, Peru, 1991; ISBN 92-9060-180-9. [Google Scholar]
- Zhang, L.; Zhao, L.; Bian, X.; Guo, K.; Zhou, L.; Wei, C. Characterization and Comparative Study of Starches from Seven Purple Sweet Potatoes. Food Hydrocoll. 2018, 80, 168–176. [Google Scholar] [CrossRef]
- Agu, K.C.; Nweke, G.U.; Okeke, B.C.; Mgbemena, I.C.C.; Okigbo, R.N.; Ngenegbo, U.C. Fungi Associated with the Post-Harvest Loss of Sweet Potato. Int. J. Res. Stud. Biosci. 2015, 3, 33–38. [Google Scholar]
- González-Estrada, R.; Blancas-Benítez, F.; Montaño-Leyva, B.; Moreno-Hernández, C.; Del Carmen Romero-Islas, L.; Romero-Islas, J.; Avila-Peña, R.; Ramos-Guerrero, A.; Fonseca-Cantabrana, A.; Gutierrez-Martinez, P.; et al. A Review Study on the Postharvest Decay Control of Fruit by Trichoderma. In Trichoderma—The Most Widely Used Fungicide; Manjur Shah, M., Sharif, U., Rufai Buhari, T., Eds.; IntechOpen: Lodnon, UK, 2019; ISBN 978-1-78923-917-1. [Google Scholar]
- Marra, R.; Ambrosino, P.; Carbone, V.; Vinale, F.; Woo, S.L.; Ruocco, M.; Ciliento, R.; Lanzuise, S.; Ferraioli, S.; Soriente, I.; et al. Study of the Three-Way Interaction between Trichoderma atroviride, Plant and Fungal Pathogens by Using a Proteomic Approach. Curr. Genet. 2006, 50, 307–321. [Google Scholar] [CrossRef]

| Location | Number of Fungi Isolated | ||||
|---|---|---|---|---|---|
| Fusarium spp. | Penicillium spp. | Aspergillus sp. | Mucor sp. | Macrophomina sp. | |
| Cheonan-si | 12 | 7 | 4 | – | – |
| Haenam-gun | 24 | – | – | 1 | – |
| Buan-gun | 10 | – | – | – | 10 |
| No. of fungi | 46 | 7 | 4 | 1 | 10 |
| Isolation (%) | (67.6%) | (10.3%) | (5.9%) | (1.5%) | (14.7%) |
| Total | 68 | ||||
| Fungal Isolates | Disease Length (mm) | Disease Depth (mm) |
|---|---|---|
| Fusarium oxysporum CMML21–2 | 13.52 ± 0.95 c | 6.67 ± 1.92 b |
| Aspergillus wentii CMML21–4 | 15.32 ± 0.61 c | 7.80 ± 0.95 b |
| Penicillium citrinum CMML21–5 | 12.96 ± 1.02 c | 6.20 ± 0.66 b |
| Penicillium rotoruae CMML21–7 | 15.55 ± 0.32 c | 7.23 ± 0.39 b |
| Fusarium ipomoeae CMML21–8 | 23.47 ± 2.09 b | 9.30 ± 1.11 b |
| Mucor variicolumellatus CMML21–12 | 12.65 ± 0.58 c | 5.03 ± 1.47 b |
| Fusarium oxysporum CMML21–13 | 16.85 ± 2.22 bc | 9.27 ± 1.13 b |
| Macrophomina phaseolina CMML21–16 | 112.95 ± 2.25 a | 42.80 ± 0.30 a |
| Fusarium solani CMML21–17 | 14.0 6 ± 2.03 c | 6.90 ± 1.15 b |
| Fungal Isolates | Inhibition Rate (%) | |
|---|---|---|
| CMML20–26 | CMML20–27 | |
| Fusarium oxysporum CMML21–2 | 81.14 ± 3.07 a | 72.05 ± 0.92 ab |
| Aspergillus wentii CMML21–4 | 77.04 ± 0.69 abc | 73.93 ± 2.50 a |
| Penicillium citrinum CMML21–5 | 53.87 ± 2.04 d | 53.87 ± 0.48 de |
| Penicillium rotoruae CMML21–7 | 69.40 ± 0.51 bc | 58.13 ± 1.35 cd |
| Fusarium ipomoea CMML21–8 | 56.99 ± 3.44 d | 57.06 ± 1.60 cd |
| Mucorvariicolumellatus CMML21–12 | 50.21 ± 1.27 d | 42.66 ± 1.28 e |
| Fusarium oxysporum CMML21–13 | 75.29 ± 0.49 abc | 72.88 ± 2.99 ab |
| Macrophominaphaseolina CMML21–16 | 78.22 ± 0.91 ab | 75.01 ± 2.50 a |
| Fusarium solani CMML21–17 | 68.83 ± 0.89 c | 64.94 ± 0.65 bc |
Publisher’s Note: MDPI stays neutral with regard to jurisdictional claims in published maps and institutional affiliations. |
© 2021 by the authors. Licensee MDPI, Basel, Switzerland. This article is an open access article distributed under the terms and conditions of the Creative Commons Attribution (CC BY) license (https://creativecommons.org/licenses/by/4.0/).
Share and Cite
Paul, N.C.; Park, S.; Liu, H.; Lee, J.G.; Han, G.H.; Kim, H.; Sang, H. Fungi Associated with Postharvest Diseases of Sweet Potato Storage Roots and In Vitro Antagonistic Assay of Trichoderma harzianum against the Diseases. J. Fungi 2021, 7, 927. https://doi.org/10.3390/jof7110927
Paul NC, Park S, Liu H, Lee JG, Han GH, Kim H, Sang H. Fungi Associated with Postharvest Diseases of Sweet Potato Storage Roots and In Vitro Antagonistic Assay of Trichoderma harzianum against the Diseases. Journal of Fungi. 2021; 7(11):927. https://doi.org/10.3390/jof7110927
Chicago/Turabian StylePaul, Narayan Chandra, Soyoon Park, Haifeng Liu, Ju Gyeong Lee, Gui Hwan Han, Hyunsook Kim, and Hyunkyu Sang. 2021. "Fungi Associated with Postharvest Diseases of Sweet Potato Storage Roots and In Vitro Antagonistic Assay of Trichoderma harzianum against the Diseases" Journal of Fungi 7, no. 11: 927. https://doi.org/10.3390/jof7110927
APA StylePaul, N. C., Park, S., Liu, H., Lee, J. G., Han, G. H., Kim, H., & Sang, H. (2021). Fungi Associated with Postharvest Diseases of Sweet Potato Storage Roots and In Vitro Antagonistic Assay of Trichoderma harzianum against the Diseases. Journal of Fungi, 7(11), 927. https://doi.org/10.3390/jof7110927

